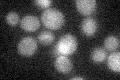
YHR075C
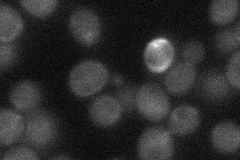
YHR075C
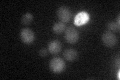
YHR075C

View description
Protein with carboxyl methyl esterase activity that may have a role in demethylation of the phosphoprotein phosphatase catalytic subunit; also identified as a small subunit mitochondrial ribosomal protein
Localization:
Intensity:
Fold change:
Significance:
-
C’ GFP library in SD
below threshold17.31 -
N' NOP1pr-GFP in SD

cytosol59.1169 -
N' TEF2pr-mCherry in SD

cytosolN/A -
N' NATIVEpr-GFP in SD
cytosol26.9988 -
N' TEF2pr-VC and Cyto-VN in SD

cytosol43.5708 -
C’ GFP library in SD+DTT

cytosol18.441.06No -
C’ GFP library in SD+H2O2

cytosol20.31.17No -
C’ GFP library in Starvation Media
cytosol25.891.49No -
C’ GFP library on the background of Pup2-DaMP

below threshold -
C’ GFP library on the background of CCT mutant

below threshold16.9020.9759No
